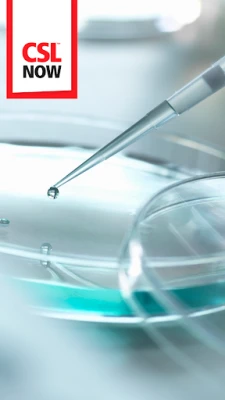

Latest Version
Version
5.4.1
5.4.1
Update
September 28, 2025
September 28, 2025
Developer
CSL Behring LLC
CSL Behring LLC
Categories
Business
Business
Platforms
Android
Android
Downloads
0
0
License
Free
Free
Package Name
com.socialchorus.bbie.android.googleplay
com.socialchorus.bbie.android.googleplay
Report
Report a Problem
Report a Problem
More About CSL NOW
CSL NOW is a better way to stay informed and connected with the CSL community -- in just 2 minutes a day.
Why you’ll love the CSL NOW App:
- Stay up-to-date on the latest business, industry and local news & information
- Receive personalized notifications on breaking news and announcements
- Connect with your community by posting photos, stories and feedback
- Share relevant content and become a social thought leader
- Designed to fit your on-the-go lifestyle
- Stay up-to-date on the latest business, industry and local news & information
- Receive personalized notifications on breaking news and announcements
- Connect with your community by posting photos, stories and feedback
- Share relevant content and become a social thought leader
- Designed to fit your on-the-go lifestyle
Rate the App
Add Comment & Review
User Reviews
Based on 0 reviews
No reviews added yet.
Comments will not be approved to be posted if they are SPAM, abusive, off-topic, use profanity, contain a personal attack, or promote hate of any kind.
More »










Popular Apps

Moon Chai StoryOlha Dobel

phpFoxPHPFOX LLC

Govee LiteGovee

World War Heroes — WW2 PvP FPSAzur Interactive Games Limited

Build World AdventureExplore city in cube world

Viking Clan: RagnarokKano Games

Vikings: War of ClansPlarium LLC

Submarine Car Diving SimulatorSwim with dolphins & penguins

Asphalt 9: LegendsGameloft SE

Union VPN - Secure VPN ProxyPureBrowser
More »










Editor's Choice

Grim Soul: Dark Survival RPGBrickworks Games Ltd

Craft of Survival - Gladiators101XP LIMITED

Last Shelter: SurvivalLong Tech Network Limited

Dawn of Zombies: Survival GameRoyal Ark

Merge Survival : WastelandStickyHands Inc.

AoD Vikings: Valhalla GameRoboBot Studio

Viking Clan: RagnarokKano Games

Vikings: War of ClansPlarium LLC

Asphalt 9: LegendsGameloft SE

Modern Tanks: War Tank GamesXDEVS LTD